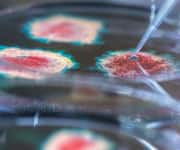

Life Extension Magazine®
Scientific research has shown a wide range of benefits for probiotics in recent years.

As a result, there’s now a glut of products on the market with probiotics added to them, from dietary supplements to breakfast cereals.
But probiotics aren’t all the same, and it’s important to take ones that have been tested and verified as effective in scientific studies.
In this interview with Life Extension®, Dr. Andrew Swick talks about the benefits of different probiotic strains, how you can ensure you’re getting the right kinds, and more.
LE: Probiotics are very popular now. What exactly are they?
Dr. Swick: Probiotics are live microorganisms that provide health benefits when consumed in appropriate amounts. The majority of probiotics are healthy bacteria. These “good” bacteria are beneficial in many ways, including some that help fight off “bad” bacteria. Probiotics take part in the larger community of microorganisms that live in many areas of your body, including your gut, skin, and mouth. This larger community is most commonly referred to as your “microbiome.”

LE: People often hear that fermented foods like yogurt contain probiotics. Is that correct?
Dr. Swick: Yogurt and other fermented foods, including kefir, kimchi, kombucha, sauerkraut, and pickles, do contain live microbes. These active cultures are popularly referred to as probiotics. But while these foods may provide some health benefits, they don’t always meet the strict scientific definition of probiotics.
The International Scientific Association for Probiotics and Prebiotics (ISAPP) only designates strains that have been characterized (properly identified and named), scientifically studied, and demonstrated to provide health benefits, as probiotics. Fermented foods contain mixtures of microbes that are for the most part uncharacterized, and may not meet the level of scientific evidence required by the ISAPP to be considered probiotics.
LE: You mentioned strains. What are those and how do consumers know if they are getting the correct strain?
Dr. Swick: Consumers should look at the full name of each probiotic listed on a product label. Each probiotic has three names in the following order:genus, species, and strain. For example: In Lactobacillus rhamnosus CRL1505, Lactobacillus is the genus, rhamnosus is the species, and CRL 1505 is the strain.
Consumers sometimes overlook the strain, but it’s very important. The specific strain is what was studied to determine the health benefits associated with the probiotic. Strains are not interchangeable, and they have specific benefits.
Think of it like this: All dogs are the same genus and species, Canis familiaris. But different breeds may be nothing alike. For bacteria, strain can be thought of as the breed. Not knowing the strain would be like adopting a dog without knowing the breed. A Chihuahua is very different from a Great Dane!
LE: Probiotics sold as dietary supplements may contain different amounts of colony forming units (CFUs), as well as a variety of strains. Is more always better?
Dr. Swick: No. That’s a common misconception. The amount and specific strains listed on the label should be consistent with what was tested in a study. A larger amount or number of probiotic strains does not mean it’s more effective.
LE: People mostly think of probiotics as helping with digestive health. But now there are targeted probiotics that can improve conditions as varied such as gum disease, depression, and allergies. How do these work?
Dr. Swick: Initially, probiotics were thought to be beneficial only for gastrointestinal health. We now know that specific strains of probiotics are helpful for a variety of conditions. Specific strains have been clinically demonstrated to support a healthy heart, throat, immune response, liver, and even mood.
In general, condition-specific probiotics work by supporting an overall healthier microbiome, producing substances that have specific effects,1 and beneficially influencing immune responses. Targeted probiotics present a meaningful advance for supporting disease prevention and health.
LE: Can you give some examples of specific strains and the conditions they benefit?
Dr. Swick: Many human mouths are teeming with a type of bacteria, Streptococcus mutans, that is a cause of cavities, gingivitis (gum inflammation), and periodontitis (gum disease).2 Nearly a third of U.S. adults have untreated tooth decay, and nearly half of those 30 and older have periodontal disease.
In a clinical study, scientists demonstrated that Streptococcus salivarius M18 was able to decrease the plaque index score and improve other measures of oral health. This is particularly important since we now know that gum disease is associated with other health conditions, including heart disease.
Another interesting application of condition-specific probiotics is in mitigating depression and anxiety. In two randomized controlled trials, participants taking a blend ofLactobacillus helveticus Rosell-52 and Bifidobacterium longum Rosell-175 reported significant improvements in mood, stress response, and emotional balance. One human study showed a 50% improvement in depression scores with these two probiotics, and another showed a 55% improvement in anxiety scores.3,4 The connection between the gut and brain is an exciting area of active research.
Scientists have also discovered and characterized a probiotic, Lactobacillus rhamnosus CRL 1505, that stimulates the immune system in the respiratory tract and gut. In clinical studies, administration of this probiotic strain led to reduction in infection symptoms, infection incidence, and use of antibiotics. The data were so compelling that Lactobacillus rhamnosus CRL 1505 was provided to schoolchildren as part of a national nutrition program in Argentina.
As research continues, new targeted probiotics are being developed for conditions such as constipation, and to support longevity.
LE: We also hear a lot lately about prebiotics. What are those?
Dr. Swick: Prebiotics are basically compounds that serve as “food” to support the growth of probiotics. Most prebiotics are dietary fibers, but not all dietary fibers are considered to be prebiotics.
LE: You’ve given us a lot of information. Can you provide the reader with some simple guidelines about how to select appropriate probiotic products?
Dr. Swick: Choosing a probiotic can be overwhelming! Here are a few key points to remember:
- First and foremost, only purchase probiotics that are high quality and backed by science.
- Ensure that the strain is clearly identified and appropriate for the specific conditions you want to address.
- Remember that more is not better. The CFUs should be consistent with what was clinically studied.
If you have any questions on the scientific content of this article, please call a Life Extension® Wellness Specialist at 1-866-864-3027.
Dr. Swick is the Chief Scientific Officer for Life Extension® and oversees all scientific and product development initiatives. Immediately prior, Dr. Swick was the Vice President of Nutrition Science at Metagenics. Dr. Swick also has deep pharmaceutical industry experience, having performed both scientific and managerial roles at Pfizer for more than 17 years, where he was responsible for drug discovery and research for obesity and atherosclerosis. Previously, he also served as an Associate Professor at the Nutrition Research Institute at the University of North Carolina at Chapel Hill. Dr. Swick earned his PhD in Nutritional Biochemistry from the University of Wisconsin-Madison and was a Postdoctoral Research Fellow at the Johns Hopkins University School of Medicine and University of North Carolina Lineberger Comprehensive Cancer Center.
References
- Galland L. The gut microbiome and the brain. Journal of medicinal food. 2014;17(12):1261-72.
- Available at: https://www.ncbi.nlm.nih.gov/books/NBK8259/. Accessed April 27, 2021.
- Messaoudi M, Lalonde R, Violle N, et al. Assessment of psychotropic-like properties of a probiotic formulation (Lactobacillus helveticus R0052 and Bifidobacterium longum R0175) in rats and human subjects. Br J Nutr. 2011 Mar;105(5):755-64.
- Messaoudi M, Violle N, Bisson JF, et al. Beneficial psychological effects of a probiotic formulation (Lactobacillus helveticus R0052 and Bifidobacterium longum R0175) in healthy human volunteers. Gut Microbes. 2011 Jul-Aug;2(4):256-61.

